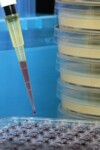
electrophoresis kits

An Interdisciplinary Science Exploration
Evidence suggests that people have been making cheese for at least several thousand years. In the 1970s, an archeologist named Peter Bogucki excavated a site in Poland and found fragments of pottery left by people who had lived there approximately 7,000 years earlier. The fragments he found, like some pottery found by others before him, were dotted with many small holes. However, there was no evidence as to what the pottery had been used for. Many years later, in 2011, chemical analysis of the same pottery fragments by Mélanie Roffet-Salque found evidence of milk fats, suggesting that the pottery was used to separate milk solids from whey, a step in the making of cheese.
Most students are familiar with cheese, but few realize how much science is involved in making good cheese. Cheese making involves many basic science concepts, including pH, protein structure, solubility, diffusion and osmosis, the effect of temperature on chemical reactions, and even some basic math. Understanding cheese making also requires an understanding of enzymes, and a familiarity with microbes and how they interact with their environment. The subject can also be integrated into discussions of history and the influence of the natural and economic environment on the development of new methods.
It is speculated that cheese making was first discovered when someone used the fourth chamber of a calf, kid (baby goat), or lamb stomach to store milk. A critical step in making cheese is to coagulate–or curdle–the milk. Traditionally, this is done using rennet–a mixture of enzymes isolated from the fourth chamber of the stomach of a calf, lamb, or kid. A common hypothesis is that cheese was created and further developed when someone storing milk in the stomach of such an animal found that the milk had coagulated and had a longer storage life.
Throughout history, humans living in various environments have put much time and effort into developing and perfecting a variety of cheeses with different tastes and textures. Often the cheeses were developed in response to specific environmental demands. For example, a group of cheeses called the alpine cheeses developed in mountainous regions. During the warmer months, herds of cows were grazed in remote mountain pastures. For convenience, the cheese made from the milk of these herds was made in the same location. The cheeses made were large, hard cheeses with a low moisture content and a rind (a hard layer of dehydrated cheese on the outside of the cheese). These characteristics made them easy to transport from the remote regions where they were made and gave them a long storage life–a characteristic important for cheese that was not immediately consumed or brought to market.
Milk is composed largely of fat, protein, the sugar lactose, minerals and water. Cheese making consolidates the solids present in milk. The final texture and taste of a cheese is the result of careful manipulation of the chemical, microbiological, and enzymatic characteristics of the milk and curd, as they are put through the multiple steps to becoming cheese. The basic steps of cheese making–and some information about the science involved in each step–are described below.
Ripening the milk
In the first step, milk is ripened–meaning it is prepared for coagulation by adding bacteria. Depending on the type of cheese being made, specific types of bacteria or mixtures of bacteria are added. As the bacteria grow, they ferment the lactose in the milk to lactic acid. This effectively lowers the pH of the milk. The pH of the milk at this stage affects many of the subsequent steps in the cheese making process.
Coagulating the milk (forming the curd)
Once the milk is ripened, it is coagulated either by further acidifying the milk or by adding rennet. The enzyme in calf rennet that actually causes the milk to curdle is chymosin (also called rennin)–a protease used by the calf to digest its mother’s milk. In order to understand why milk coagulates in response to either of these treatments, you need to understand the form most of the milk’s protein is in. Most of the protein in milk is casein, of which there are multiple types. In combination with phosphate and calcium ions present in the milk, the caseins in milk form spherical micelles–small particles that stay suspended in the milk. The exact structure of the micelles is still not completely understood, but it is generally agreed upon that the kappa-casein proteins (1 type of casein protein in the micelles) are arranged such that their polar (charged) regions are on the surface of the micelles. Calcium and phosphate ions are also present on the surface of the micelles. The polar region of the kappa-caseins on the surface of the micelle–as well as the calcium and phosphate ions present there–interact with water molecules that are also polar. The interaction of the micelles with the polar water molecules allows the micelles to stay suspended in the liquid phase of the milk. However, treatment with rennet or acid disrupts the micelle structure such that the surface is no longer charged, making the micelles insoluble. As a result, the micelles clump together and–if left undisturbed–the milk coagulates to form a single solid mass called a curd. The remaining liquid is referred to as whey.
Cutting and heating the curd
In the next step, the curd is cut into smaller pieces in order to facilitate its further drying. The curd of dry cheese–such as Swiss–is cut into small rice-like particles. This is a real-world illustration of surface area’s importance. At this point, for some cheeses, the curd is heated to further expel the whey.
Washing
Next, some cheeses–such as Colby and Monterey Jack–are washed to remove some of the lactose and lactic acid. (Note: Some cheeses may be washed before they are heated). Washing raises the pH of the curd both directly (by removing the lactic acid) and indirectly (by removing the lactose that the bacteria in the cheese would ferment into lactic acid). This change in pH affects the types of microorganisms that will subsequently grow in the cheese. This washing step–and its subsequent effect on which microorganisms will grow in the cheese–provides a clear, real-life example of both diffusion and the effect of the environment on the growth of microorganisms. The microorganisms in the cheese and the cheese’s pH will have a profound impact on how the cheese ages and therefore impact its taste and texture.
Draining and pressing
Next, the whey is separated from the curds, and the curds are placed into a mold or hoop to be formed into the cheese’s final shape. Some cheeses–such as Gouda cheese–are pressed once they are placed in the hoops or molds, meaning pressure is applied to the cut curds to encourage them to knit back together to form a single piece of cheese.
Salting
Salt is used in almost all cheeses and plays multiple roles in cheese making. The process through which salt exerts its effect on cheese is a great example of osmosis and diffusion in action. As one of its roles in cheese making, salt lowers the moisture content of the cheese. When salt is applied to the cheese–either directly to its surface or as brine–osmotic pressure draws moisture, and with it lactose, lactic acid, and minerals, out of the cheese. Some of the salt also diffuses into the cheese. Thus, salting also affects the microbiological environment of the cheese, limiting the type of organisms that can grow in the cheese and influencing the microbes’ metabolism and replication. In general, as the amount of salt in the cheese increases, fewer microbes are able to grow in it. Salt also directly affects the activity of enzymes in the cheese.
Cheese ripening
Once the cheese has been pressed into its final shape and salted, it is left to ripen or age. As the cheese ripens, the flavor and texture of the cheese develops. Much of this development is a result of enzymatic and microbial activity. Ripening also involves multiple other factors, including the amount and quality of the fat and protein present in the milk, the pH, the salt content, the moisture and calcium phosphate content of the curd, and the microbes present during cheese making and ripening.
The microbes present in the cheese during ripening have a profound effect on the nature of the cheese in sometimes dramatic ways. For example, the molds Penicillium camemberti and Penicillium roqueforti are what give Camembert and Roquefort cheeses their distinctive flavor. The distinctive flavor of Swiss-style cheeses results from the bacterium Propionibacterium freudenreichii (subspecies shermanii) producing propionic and acetic acid as they ferment lactic acid. This fermentation also produces carbon dioxide, which creates the holes characteristic of these cheeses.
Many of the effects microorganisms have on the cheese during ripening are a result of the enzymes within the microbes. Enzymes in the bacteria of Swiss-style cheeses carry out the fermentation of lactic acid. Even after microbes die, some of their enzymes remain active in the cheese. In addition, there are some enzymes initially present in the milk and enzymes carried over from the rennet used to coagulate the milk. These include lipases and multiple proteases. Throughout cheese making, proteases break down the casein protein in the milk into progressively smaller pieces. During the aging process of some cheeses, casein is broken down into amino acids, which are then converted by bacteria into compounds that impart distinct flavors to the cheese. Lipase enzymes also play a role in shaping the flavor of a cheese. Sharp flavor–such as that of Provolone cheese–results when short-chain free fatty acids are cleaved from milk fat by lipases.
Have your students try their hand at cheese making. There are simple recipes online for acid-coagulated cheeses. Advanced students who are game for a more involved project may want to try making some of the more complex, rennet-coagulated cheeses. However, remember that if they want to taste or consume their cheese, students will most likely have to experiment at home in their own kitchens, as labs–unless specifically designed to prepare food for consumption–are not safe places to prepare food that will be tasted or eaten.
Multiple science concepts can be explored through cheese making. In the Carolina kit, Enzymes and the Science of Cheesemaking (items #202306 and #202306P), students investigate the effect that pH has on the rennet-mediated coagulation of milk and then develop questions about what else might affect the coagulation of milk and then they plan and carry out an investigation to answer those questions. Be aware that because the materials included in the kit will not be not food-grade, none of the curd created using this kit should be tasted or consumed by students.
References
Curry, Andrew. 2013. The milk revolution. Nature 500:20-22.
Kindstedt, Paul, and the Vermont Cheese Council. 2005. American farmstead cheese: The complete guide to making and selling artisan cheeses. White River Junction, VT: Chelsea Green Publishing Company.
About The Author
Carolina Staff
Carolina is teamed with teachers and continually provides valuable resources–articles, activities, and how-to videos–to help teachers in their classroom.